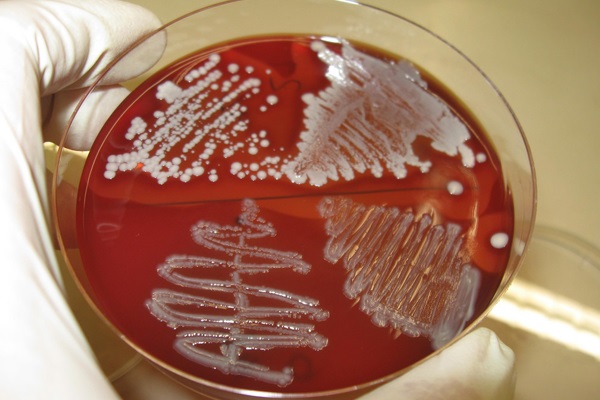
bacteriology

DIAGNOSTIC CENTER EXCLUSIVELY FOR PETS
RVD Lab is one of the first diagnostic laboratory meant exclusively for Veterinary needs. We are, Bangalore's first Professionally primed Veterinary Diagnostics Laboratory.
Testimonials
About Us
Rohana Veterinary Diagnostic Lab (RVD) is Bengaluru’s first lab with state of art Veterinary diagnostic technology and exclusively catering to the ever increasing needs of Veterinary population.
Through RVD, we offer quality diagnostic services like routine hemogram, serum biochemistry, immunology, bacteriology, serology, virology, histopathology, parasitology, analytical services, molecular diagnostics and toxicology for animal species.
All the tests are conducted under the guidance of Veterinary professionals, following standard operating procedures (SOPs). Our lab functions in a expansive area of 2400 sqft, with separate rooms for analytical, toxicology and microbiology services.
PROCESS






First choice for your pet's health tests
Our Laboratory is ready to meet the diagnostic routine through basic and advanced testing techniques and at the same time, ready to accept the diagnostic challenges of the veterinarians and their patients by offering quality analytical/diagnostic services


OUR CLIENTS

NATIONAL INSTITUTES

VETERINARIANS

ANIMAL SHELTERS
RVD LAB FACILITY
Our Lab has a team of highly experienced,dedicated and skilled professionals,which includes of Veterinary Pathologists,Microbiologist ,virologist and certified lab Technicians.
Our Laboratory is ready to meet the diagnostic routine though basic and advanced testing techniques and at the same time, ready to accept the diagnostic challenges of the veterinarians and their patients by offering Quality analytical/diagnostic services.